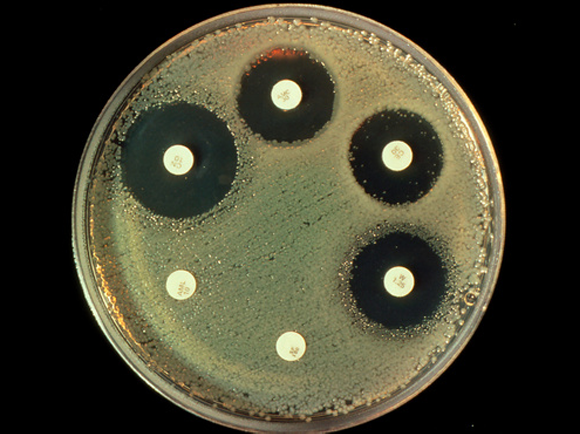

فيروسات البكتريوفاج – العاثّيّات البكتيريّة (آكلة البكتريا)، والتي تُسمّى اختصارًا العاثيات أو الفاجيات (Phages- لاحقة معناها: الآكِل)، هي فيروسات تصيب البكتيريا. ككلّ أنواع الفيروسات، تعتمد العاثّيّات على الموارد والأنظمة البيولوجيّة للخليّة التي تقوم بمهاجمتها من أجل مضاعفة نفسها. في مختبرات الأبحاث، تُجرى معظم التجارب على تكاثر العاثّيّات في طبق زراعة البكتيريا من النوع الذي ينقسم بشكل متكرّر، أي البكتيريا التي تنشط أنظمتها البيولوجيّة بشكل كبير، ويصل إليها إمدادٌ مستمرّ من العناصر الغذائيّة ومصادر الطاقة. لكن في الطبيعة، فإنّ معظم أنواع البكتيريا تتكاثر ببُطء أو أنّها أحيانًا تكون في نوع من سبات معيّن، تعلّق خلاله معظم العمليّات البيولوجيّة، حتّى تصادف البكتيريا ظروفًا بيئيّة جيّدة للتكاثر. مثل هذه الظروف، ذات النشاط المنخفض للخليّة المُضيفة، تُعتبر غير مناسِبة لتكاثر الفيروسات. مع ذلك، هناك دراسة جديدة تشرح عن العاثّيّات التي يمكنها قتل البكتيريا وهي في حالة سبات.
السّبات جيّد للمقاومة
إنّ مقاومة البكتيريا المسبِّبة للأمراض للمضاداتِ الحيوية تُعدّ مشكلة خطيرة في عصرنا الحديث. التركيز الأساسيّ في الأبحاث التي تحاول إيجاد حلول للمشكلة، ينصب على الجينات التي تمنح مقاومة للمضادات الحيويّة، والتي تنقلها البكتيريا بين بعضها البعض. ولكنّ البكتيريا التي تتكاثر ببطء، أو التي تكون في حالة سبات، يمكنها أن تكون أيضًا مقاوِمة لمجموعة متنوّعة من المضادّات الحيويّة بطرق أخرى. مثلًا، المضادّات الحيويّة التي يكون عملها القضاء على عمليّة مضاعفة الحمض النوويّ، لن تلحق الضّرر بالبكتيريا الخاملة التي لا تتكاثر لأنّها، أي البكتيريا، لا تضاعف حمضها النوويّ وهي في سبات. وينطبق هذا أيضًا على العديد من أنواع المضادّات الحيويّة الأخرى. ولذلك، فعندما يتلقّى المريض علاجًا بالمضادّات الحيويّة، فإنّ مجموعة البكتيريا التي تتكاثر بسرعة – يتمّ القضاء عليها بسرعة، ولكن هناك نسبة صغيرة من البكتيريا المسبّبة للأمراض، التي قد تكون في نوع من سبات معيّن، وبالتالي تكون مقاوِمة للعلاج.
واحدة من أخطر المشاكل في عصرنا. تقاوم بكتيريا الـ E. coli نوعين من المضادّات الحيويّة (الدوائر البيضاء السفليّة) ولكنّها حسّاسة للأنواع الأربعة الأخرى، والتي يوجد حولها منطقة خالية من البكتيريا | تصوير:JOHN / SCIENCE PHOTO LIBRARY
العاثّيّات بدلًا من المضادّات الحيويّة
أحد أنواع العلاجات التي تُدرس حاليًّا للأمراض البكتيرية، كعلاجٍ مشترك مع المضادّات الحيويّة، أو حتّى بدلًا من المضادّات الحيويّة، هو العلاج بالعاثّيّات. تقوم الفكرة على إعطاء المريض العاثّيّات، من أجل أن تقتل البكتيريا المسبِّبة للمرض، والتي تفشل المضادّات الحيويّة في قتلها لأسباب مختلفة. إنّ معظم العاثيّات التي تُدرس اليوم، هي تلك التي تتكاثر بنجاح في مزرعة البكتيريا سريعة الانقسام. ولكن ماذا عن البكتيريا التي تنقسم ببطء شديد، أو تلك التي لا تنقسم على الإطلاق، بحيث لا تتمكّن العاثيّات من التكاثر داخلها؟
في مجموعة بحث تابعة لألكساندر هارمز (Harms) من جامعتي بازل وزيوريخ في سويسرا، سألوا عمّا إذا كانت هناك عاثّيّات تستطيع إصابة البكتيريا الموجودة في سبات والتكاثر داخلها. نُشرت نتائج البحث في مجلة Nature communications. استخدم الباحثون لأغراض البحث بكتيريا الإشريكيّة القولونيّة (Escherichia coli)، التي تسبّب التّسمم الغذائيّ أو التهابات المسالك البوليّة، وبكتيريا الزائفة الزنجاريّة (Pseudomonas aeruginosa)، التي تسبّب التهابات في المسالك البوليّة أو التهابات الرئتين، هذان النوعان من البكتيريا طوّرا سلالات مقاوِمة لمعظم أدوية المضادّات الحيويّة.
قام الباحثون بزراعة البكتيريا في ظروف نموّ طبيعية تسمح بالانقسام السريع للبكتيريا، أو في ظروف تجويع حتّى دخلت البكتيريا في سبات. بعد ذلك عالجوا البكتيريا بمجموعة متنوّعة من المضادّات الحيويّة، أو بأنواع عاثّيّات من التي تُدرس تكرارًا في المختبرات. جميع أنواع المضادّات الحيويّة أو العاثيّات التي اختبرت قد قتلت البكتيريا التي نمت بشكل طبيعيّ، ولكنها لم تقتل البكتيريا الخاملة. يبدو أنّ العاثّيّات اخترقت البكتيريا، لكنّها دخلت أيضًا في سبات. بعد أن فشلت العاثّيّات المعروفة في القضاء على البكتيريا الخاملة، استخدم الباحثون مجموعة مكوّنة من 68 عاثّيًّا، كانوا قد عزلوها سابقًا من مياه الأنهر ومياه الصرف الصحي والأراضي. من بين هذه المجموعة، وجد الباحثون عاثيّة واحدة قد نجحت في التكاثر في مزرعة بكتيريا الزّائفة Pseudomonas الخاملة، وقتلت 99% من البكتيريا الموجودة في المزرعة. سمّى الباحثون العاثية باسم بارايد (Paride). في بحث آخر عن العاثيّات من بيئات مختلفة، وجدوا ثلاث عاثيّات أخرى تمكّنت من قتل بكتيريا الزّائفة وهي في حالة سبات.

تمكّنت من قتل 99 بالمئة من البكتيريا النائمة في المزرعة. عاثّيّة البكتيريا بارايد (بالبنفسجي) في صورة بالمجهر الإلكترونيّ | צילום: Enea Maffei / ETH Zurich
ذهب الاثنان معًا
إنّ قضاء العاثّيّات على 99% من مزرعة البكتيريا هو أمرٌ جيّد جدًّا، لكنّنا نريد الوصول إلى نسبة 100%. لذلك، فحص الباحثون بما إذا كان الدمج بين العلاج بالعاثّيّة مع المضادّات الحيويّة سيكون ذا نجاعة أكبر. لم يقضِ العلاج بالمضادّ الحيوي ميروبينم (Meropenem) وحده على البكتيريا، ولكن عندما قام الباحثون بدمجِهِ مع العاثّيّة Paride، أدّى ذلك إلى تعقيم المزرعة من البكتيريا بشكل كامل – حيث لم يجد الباحثون خليّة بكتيريا واحدة على قيد الحياة. وفي مقابل ذلك، عندما دُمِجَت عاثيّة Paride مع نوعيْن آخريْن من المضادات الحيوية – سيبروفلوكساسين (Ciprofloxacin) أو توبراميسين (Tobramycin)، لم يكن هناك اختلاف في النتيجة بين استخدام المضادّ الحيويّ لوحده أو استخدامه مع العاثيّة. يعود السبب إلى الاختلافات بين آليّات عمل الأدوية: التوبراميسين يقضي على عمليّة مضاعفة الحمض النوويّ، في حين أنّ السيبروفلوكساسين يقضي على آليّة ترجمة المعلومات الوراثيّة إلى بروتينات – وهما آليّتان تحتاجهما العاثّيّة. بينما يقضي الميروبينيم على عمليّة بناء جدار خليّة البكتيريا، وهو أمر لا يتداخل مع العاثّيّة ولا يضرّها، بل يساعد العاثّيّات الجديدة المُنتجة في خلية البكتيريا على الخروج منها والانتشار.
بعد ذلك أراد الباحثون اختبار مدى فاعليّة العلاج على حيوانات المختبر أيضًا. لذا أصابوا فئران المختبر ببكتيريا الزائفة، وبعد ثلاثة أيّام بدأوا بعلاجها إمّا بالعاثية وحدها، أو بالمضادّ الحيويّ الميروبينيم وحده، أو بمزيج من الاثنين معًا. العلاجان كلّ على حِدة فشِلا في تقليل كمّيّة البكتيريا بنسبة كبيرة في الفئران، بينما أدّى المزيج المشترك للعلاجيْن على تقليل كمية البكتيريا بألف مرّة.
يأمل الباحثون أن تلهم دراستهم هذه باحثين آخرين، للعثور على العاثّيّات القادرة على التكاثر في البكتيريا الخاملة وقتلها، وبالتالي تطوير علاج مشترك للعاثّيّات مع المضادّات الحيويّة المناسبة، من أجل علاج الالتهابات البكتيريّة الشديدة، وخصوصًا تلك التي تسبّبها البكتيريا المقاوِمة للعلاجات المعتادة.